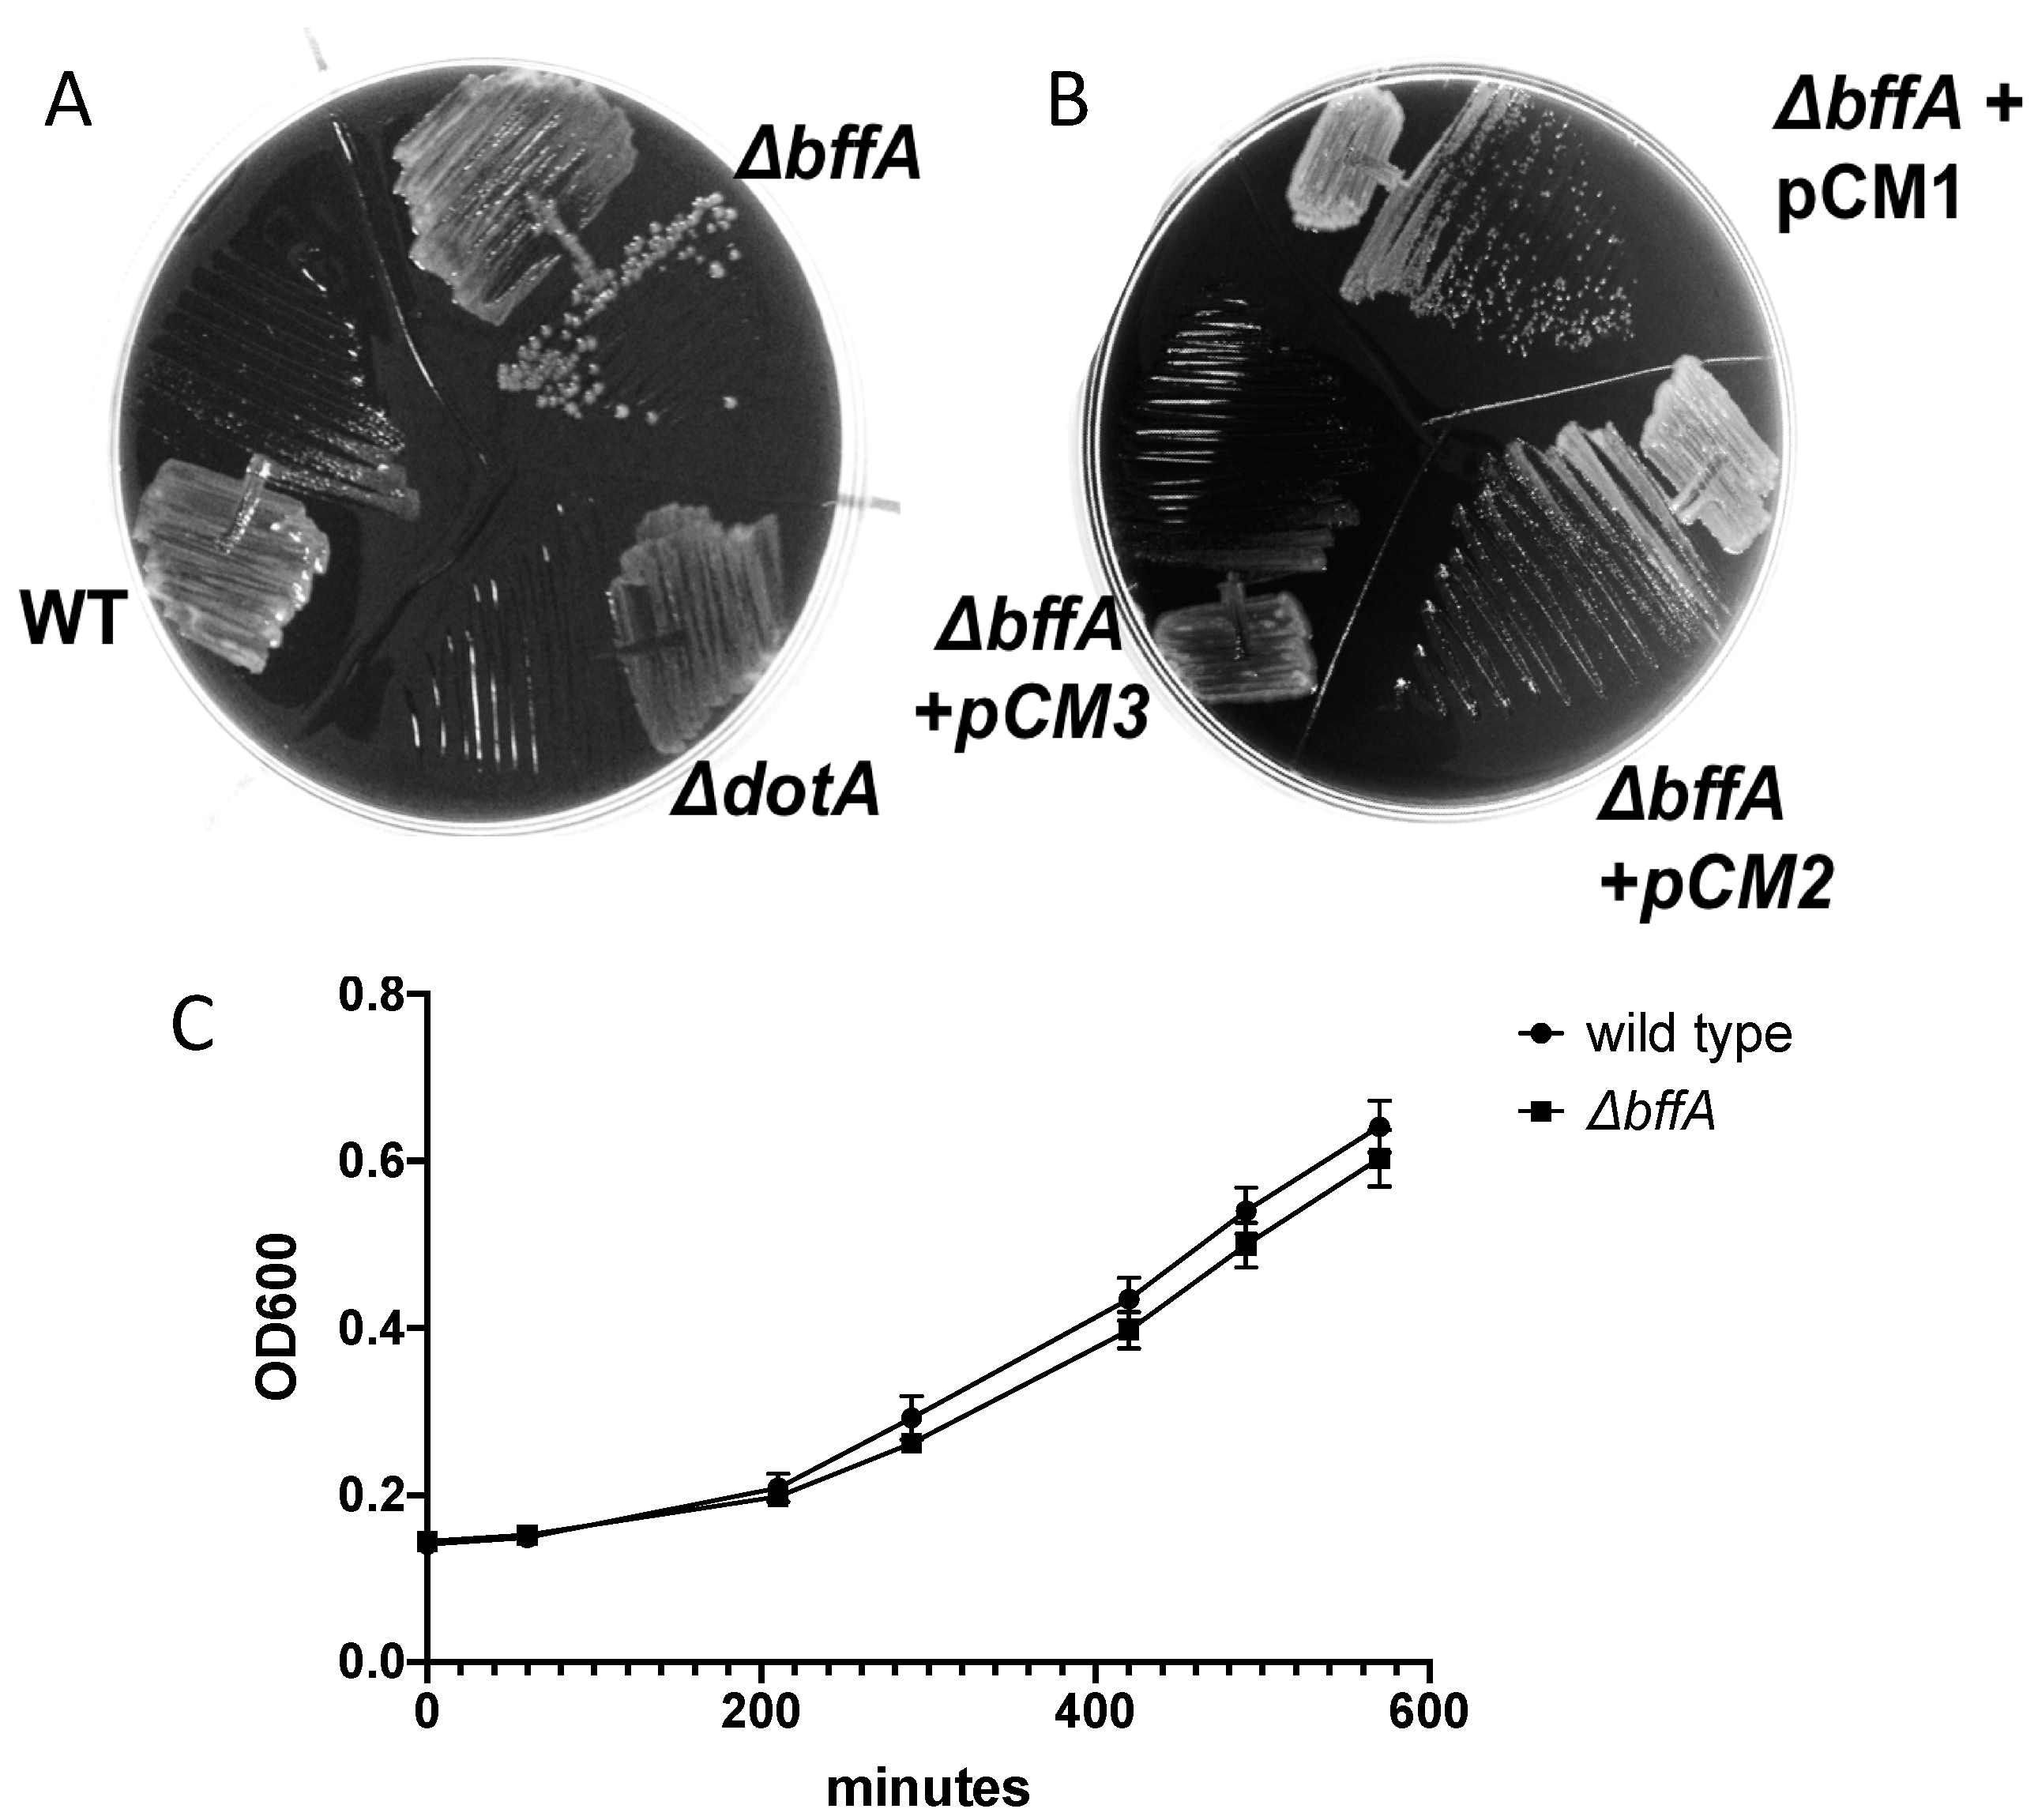
Biomolecules 12 00225 g001 550

Characterization of a Novel Regulator of Biofilm Formation in the Pathogen Legionella pneumophila
Abstract
:1. Introduction
2. Materials and Methods
2.1. Strains, Plasmids, and Primers
2.2. Media and Antibiotics
2.3. Broth Growth Curve
2.4. Intracellular Growth Curve in A. Castellanii
2.5. Flagellar Motility Assay
2.6. 96-Well Biofilm Assay
2.7. Coverslip Biofilm Assay
2.8. Biofilm Binding Assay
2.9. Gentamicin Protection Assay
3. Results
3.1. L. pneumophila ΔbffA Exhibits Altered Growth Kinetics on Solid Medium, but Not in Broth, Compared to Wild-Type
3.2. The ΔbffA Strain Has Normal Rates of Intracellular Growth in A. Castellanii
3.3. ΔbffA Forms Biofilms Faster than the Wild-Type Strain
3.4. ΔbffA Is Less Motile than Wild-Type Bacteria at 37 °C, but Not at 30 °C
4. Discussion
Supplementary Materials
Author Contributions
Funding
Institutional Review Board Statement
Informed Consent Statement
Data Availability Statement
Conflicts of Interest
References
- Donlan, R.M.; Costerton, J.W. Biofilms: Survival mechanisms of clinically relevant microorganisms. Clin. Microbiol. Rev. 2002, 15, 167–193. [Google Scholar] [CrossRef] [PubMed] [Green Version]
- Molofsky, A.B.; Shetron-Rama, L.M.; Swanson, M.S. Components of the Legionella pneumophila flagellar regulon contribute to multiple virulence traits, including lysosome avoidance and macrophage death. Infect. Immun. 2005, 73, 5720–5734. [Google Scholar] [CrossRef] [PubMed] [Green Version]
- Cristino, S.; Legnani, P.P.; Leoni, E. Plan for the control of Legionella infections in long-term care facilities: Role of environmental monitoring. Int. J. Hyg. Environ. Health 2012, 215, 279–285. [Google Scholar] [CrossRef] [PubMed]
- Farhat, M.; Moletta-Denat, M.; Frère, J.; Onillon, S.; Trouilhé, M.-C.; Robine, E. Effects of disinfection on Legionella spp., eukarya, and biofilms in a hot water system. Appl. Environ. Microbiol. 2012, 78, 6850–6858. [Google Scholar] [CrossRef] [Green Version]
- Ferranti, G.; Marchesi, I.; Favale, M.; Borella, P.; Bargellini, A. Aetiology, source and prevention of waterborne healthcare-associated infections: A review. J. Med. Microbiol. 2014, 63, 1247–1259. [Google Scholar] [CrossRef] [Green Version]
- Lu, J.; Buse, H.Y.; Gomez-Alvarez, V.; Struewing, I.; Santo Domingo, J.; Ashbolt, N.J. Impact of drinking water conditions and copper materials on downstream biofilm microbial communities and Legionella pneumophila colonization. J. Appl. Microbiol. 2014, 117, 905–918. [Google Scholar] [CrossRef]
- Albert-Weissenberger, C.; Sahr, T.; Sismeiro, O.; Hacker, J.; Heuner, K.; Buchrieser, C. Control of flagellar gene regulation in Legionella pneumophila and its relation to growth phase. J. Bacteriol. 2010, 192, 446–455. [Google Scholar] [CrossRef] [Green Version]
- Schulz, T.; Rydzewski, K.; Schunder, E.; Holland, G.; Bannert, N.; Heuner, K. FliA expression analysis and influence of the regulatory proteins RpoN, FleQ and FliA on virulence and in vivo fitness in Legionella pneumophila. Arch. Microbiol. 2012, 194, 977–989. [Google Scholar] [CrossRef] [Green Version]
- Abdel-Nour, M.; Duncan, C.; Prashar, A.; Rao, C.; Ginevra, C.; Jarraud, S.; Low, D.E.; Ensminger, A.W.; Terebiznik, M.R.; Guyard, C. The Legionella pneumophila collagen-like protein mediates sedimentation, autoaggregation, and pathogen-phagocyte interactions. Appl. Environ. Microbiol. 2014, 80, 1441–1454. [Google Scholar] [CrossRef] [Green Version]
- Declerck, P.; Behets, J.; Margineanu, A.; van Hoef, V.; De Keersmaecker, B.; Ollevier, F. Replication of Legionella pneumophila in biofilms of water distribution pipes. Microbiol. Res. 2009, 164, 593–603. [Google Scholar] [CrossRef]
- Wingender, J.; Flemming, H.-C. Biofilms in drinking water and their role as reservoir for pathogens. Int. J. Hyg. Environ. Health 2011, 214, 417–423. [Google Scholar] [CrossRef] [PubMed]
- Cooper, I.R.; Hanlon, G.W. Resistance of Legionella pneumophila serotype 1 biofilms to chlorine-based disinfection. J. Hosp. Infect. 2010, 74, 152–159. [Google Scholar] [CrossRef] [PubMed]
- Gupta, K.; Liao, J.; Petrova, O.E.; Cherny, K.E.; Sauer, K. Elevated levels of the second messenger c-di-GMP contribute to antimicrobial resistance of Pseudomonas aeruginosa. Mol. Microbiol. 2014, 92, 488–506. [Google Scholar] [CrossRef] [PubMed] [Green Version]
- Saby, S.; Suty, H. Resistance of Legionella to disinfection in hot water distribution systems. Water Sci. Technol. 2005, 52, 15–28. [Google Scholar] [CrossRef]
- Loret, J.F.; Levi, Y. Comparison of disinfectants for biofilm, protozoa and Legionella control. J. Water Health 2005, 3, 423–433. [Google Scholar] [CrossRef]
- Craun, G.F.; Brunkard, J.M.; Yoder, J.S.; Roberts, V.A.; Carpenter, J.; Wade, T.; Calderon, R.L.; Roberts, J.M.; Beach, M.J.; Roy, S.L. Causes of Outbreaks Associated with Drinking Water in the United States from 1971 to 2006. Clin. Microbiol. Rev. 2010, 23, 507–528. [Google Scholar] [CrossRef] [Green Version]
- Buse, H.Y.; Lu, J.; Struewing, I.T.; Ashbolt, N.J. Preferential colonization and release of Legionella pneumophila from mature drinking water biofilms grown on copper versus unplasticized polyvinylchloride coupons. Int. J. Hyg. Environ. Health 2014, 217, 219–225. [Google Scholar] [CrossRef]
- Carlson, H.K.; Vance, R.E.; Marletta, M.A. H-NOX regulation of c-di-GMP metabolism and biofilm formation in Legionella pneumophila. Mol. Microbiol. 2010, 77, 930–942. [Google Scholar] [CrossRef] [Green Version]
- Chatterjee, D.; Boyd, C.D.; O’Toole, G.A.; Sondermann, H. Structural characterization of a conserved, calcium-dependent periplasmic protease from Legionella pneumophila. J. Bacteriol. 2012, 194, 4415–4425. [Google Scholar] [CrossRef] [Green Version]
- Hindre, T.; Bruggemann, H.; Buchrieser, C.; Hechard, Y. Transcriptional profiling of Legionella pneumophila biofilm cells and the influence of iron on biofilm formation. Microbiol. 2008, 154, 30–41. [Google Scholar] [CrossRef] [Green Version]
- Mallegol, J.; Duncan, C.; Prashar, A.; So, J.; Low, D.E.; Terebeznik, M.; Guyard, C. Essential Roles and Regulation of the Legionella pneumophila Collagen-Like Adhesin during Biofilm Formation. PLoS ONE 2012, 7, e46462. [Google Scholar] [CrossRef] [PubMed] [Green Version]
- Pécastaings, S.; Bergé, M.; Dubourg, K.M.; Roques, C. Sessile Legionella pneumophila is able to grow on surfaces and generate structured monospecies biofilms. Biofouling 2010, 26, 809–819. [Google Scholar] [CrossRef] [PubMed] [Green Version]
- Piao, Z.; Sze, C.C.; Barysheva, O.; Iida, K.-I.; Yoshida, S.-I. Temperature-regulated formation of mycelial mat-like biofilms by Legionella pneumophila. Appl. Environ. Microbiol. 2006, 72, 1613–1622. [Google Scholar] [CrossRef] [PubMed] [Green Version]
- Stewart, C.R.; Muthye, V.; Cianciotto, N.P. Legionella pneumophila Persists within Biofilms Formed by Klebsiella pneumoniae, Flavobacterium sp., and Pseudomonas fluorescens under Dynamic Flow Conditions. PLoS ONE 2012, 7, e50560. [Google Scholar] [CrossRef] [PubMed] [Green Version]
- Tamayo, R.; Pratt, J.T.; Camilli, A. Roles of Cyclic Diguanylate in the Regulation of Bacterial Pathogenesis. Annu. Rev. Microbiol. 2007, 61, 131–148. [Google Scholar] [CrossRef] [PubMed] [Green Version]
- Hengge, R. Principles of c-di-GMP signalling in bacteria. Nat. Rev. Micro. 2009, 7, 263–273. [Google Scholar] [CrossRef]
- Mills, E.; Pultz, I.S.; Kulasekara, H.D.; Miller, S.I. The bacterial second messenger c-di-GMP: Mechanisms of signalling. Cell Microbiol. 2011, 13, 1122–1129. [Google Scholar] [CrossRef]
- Hochstrasser, R.; Kessler, A.; Sahr, T.; Simon, S.; Schell, U.; Gomez-Valero, L.; Buchrieser, C.; Hilbi, H. The pleiotropic Legionella transcription factor LvbR links the Lqs and c-di-GMP regulatory networks to control biofilm architecture and virulence. Environ. Microbiol. 2019, 21, 1035–1053. [Google Scholar] [CrossRef]
- Pécastaings, S.; Allombert, J.; Lajoie, B.; Doublet, P.; Roques, C.; Vianney, A. New insights into Legionella pneumophila biofilm regulation by c-di-GMP signaling. Biofouling 2016, 32, 935–948. [Google Scholar] [CrossRef] [Green Version]
- Berger, K.H.I.; Ralph, R. Two Distinct defects in intracellular growth complemented by a single genetic locus in Legionella pneumophila. Mol. Microbiol. 1993, 7, 7–19. [Google Scholar] [CrossRef]
- Zuckman, D.M.; Hung, J.B.; Roy, C.R. Pore-forming activity is not sufficient for Legionella pneumophila phagosome trafficking and intracellular growth. Mol. Microbiol. 1999, 32, 990–1001. [Google Scholar] [CrossRef] [PubMed]
- Marra, A.; Shuman, H.A. Isolation a Legionella pneumophila restriction mutant with increased ability to act as a recipient in heterospecific matings. J. Bacteriol. 2007, 171, 2238–2240. [Google Scholar] [CrossRef] [PubMed] [Green Version]
- Coers, J.; Kagan, J.C.; Matthews, M.; Nagai, H.; Zuckman, D.M.; Roy, C.R. Identification of Icm protein complexes that play distinct roles in the biogenesis of an organelle permissive for Legionella pneumophila intracellular growth. Mol. Microbiol. 2000, 38, 719–736. [Google Scholar] [CrossRef] [PubMed]
- Merriam, J.J.; Mathur, R.; Maxfield-Boumil, R.; Isberg, R.R. Analysis of the Legionella pneumophila fliI gene: Intracellular Growth of a Defined Mutant defective for flagellum biosynthesis. Infect. Immun. 1997, 65, 2497–2501. [Google Scholar] [CrossRef] [Green Version]
- Merritt, J.H.; Kadouri, D.E.; O’Toole, G.A. Growing and Analyzing Static Biofilms. Curr Protoc Microbiol. 2005, 22, 1B.1.1–1B.1.18. [Google Scholar]
- Kevin, G.; Roelofs, C.J.J.; Helman, S.R.; Shang, X.; Orr, M.W.; Goodson, J.R.; Galperin, M.Y.; Yildiz, F.H.; Lee, V.T. Systematic Identification of Cyclic-di-GMP Binding Proteins in Vibrio cholerae Reveals a Novel Class of Cyclic-di-GMP-Binding ATPases Associated with Type II Secretion Systems. PLoS Pathog. 2015, 11, e1005232. [Google Scholar]
- Lee, V.T.; Matewish, J.M.; Kessler, J.L.; Hyodo, M.; Hayakawa, Y.; Lory, S. A cyclic-di-GMP receptor required for bacterial exopolysaccharide production. Mol. Microbiol. 2007, 65, 1474–1484. [Google Scholar] [CrossRef] [Green Version]
- Navarro, M.V.A.S.; De, N.; Bae, N.; Wang, Q.; Sondermann, H. Structural Analysis of the GGDEF-EAL Domain-Containing c-di-GMP Receptor FimX. Structure 2009, 17, 1104–1116. [Google Scholar] [CrossRef] [Green Version]
- Paul, K.; Nieto, V.; Carlquist, W.C.; Blair, D.F.; Harshey, R.M. The c-di-GMP Binding Protein YcgR Controls Flagellar Motor Direction and Speed to Affect Chemotaxis by a Backstop Brake Mechanism. Mol. Cell 2010, 38, 128–139. [Google Scholar] [CrossRef] [Green Version]
- Creasey, E.A.; Isberg, R.R. The protein SdhA maintains the integrity of the Legionella-containing vacuole. Proc. Natl. Acad. Sci. USA 2012, 109, 3481–3486. [Google Scholar] [CrossRef] [Green Version]
- Harding, C.R.; Stoneham, C.A.; Schuelein, R.; Newton, H.; Oates, C.V.; Hartland, E.L.; Schroeder, G.N.; Frankel, G. The Dot/Icm effector SdhA is necessary for virulence of Legionella pneumophila in Galleria mellonella and A/J mice. Infect. Immun. 2013, 81, 2598–2605. [Google Scholar] [CrossRef] [PubMed] [Green Version]
- Ninio, S.; Roy, C.R. Effector proteins translocated by Legionella pneumophila: Strength in numbers. Trends Microbiol. 2007, 15, 372–380. [Google Scholar] [CrossRef] [PubMed]
- Diederen, B.M. Legionella spp. and Legionnaires disease. J. Infect. 2008, 56, 1–12. [Google Scholar] [CrossRef] [PubMed]
- Franco, I.S.; Shohdy, N.; Shuman, H.A. The Legionella pneumophila Effector VipA Is an Actin Nucleator That Alters Host Cell Organelle Trafficking. PLoS Pathog. 2012, 8, e1002546. [Google Scholar] [CrossRef] [Green Version]
- Gaspar, A.H.; Machner, M.P. VipD is a Rab5-activated phospholipase A1 that protects Legionella pneumophila from endosomal fusion. Proc. Natl. Acad. Sci. USA 2014, 111, 4560–4565. [Google Scholar] [CrossRef] [PubMed] [Green Version]
- Ku, B.; Lee, K.-H.; Park, W.S.; Yang, C.-S.; Ge, J.; Lee, S.-G.; Cha, S.-S.; Shao, F.; Heo, W.D.; Jung, J.U.; et al. VipD of Legionella pneumophila Targets Activated Rab5 and Rab22 to Interfere with Endosomal Trafficking in Macrophages. PLoS Pathog. 2012, 8, e1003082. [Google Scholar] [CrossRef] [PubMed] [Green Version]
- Molofsky, A.B.; Swanson, M.S. Differentiate to thrive: Lessons from the Legionella pneumophila life cycle. Mol. Microbiol. 2004, 53, 29–40. [Google Scholar] [CrossRef] [Green Version]
- Swanson, M.S.; Isberg, R.R. Association of Legionella pneumophila with the Macrophage Endoplasmic Reticulum. Infect. Immun. 1995, 63, 3609–3620. [Google Scholar] [CrossRef] [Green Version]
- Liu, X.; Beyhan, S.; Lim, B.; Linington, R.G.; Yildiz, F.H. Identification and Characterization of a Phosphodiesterase That Inversely Regulates Motility and Biofilm Formation in Vibrio cholerae. J. Bacteriol. 2010, 192, 4541–4552. [Google Scholar] [CrossRef] [Green Version]
- Ahmad, I.; Wigren, E.; Le Guyon, S.; Vekkeli, S.; Blanka, A.; el Mouali, Y.; Anwar, N.; Chuah, M.L.; Lünsdorf, H.; Frank, R.; et al. The EAL-like protein STM1697 regulates virulence phenotypes, motility and biofilm formation in Salmonella typhimurium. Mol. Microbiol. 2013, 90, 1216–1232. [Google Scholar] [CrossRef]
- Guttenplan, S.B.; Kearns, D.B. Regulation of flagellar motility during biofilm formation. FEMS Microbiol. Rev. 2013, 37, 849–871. [Google Scholar] [CrossRef] [PubMed] [Green Version]
- Römling, U. Cyclic di-GMP, an established secondary messenger still speeding up. Environ. Microbiol. 2011, 14, 1817–1829. [Google Scholar] [CrossRef] [PubMed] [Green Version]
- Newell, P.D.; Monds, R.D.; O’Toole, G.A. LapD is a bis-(3,5)-cyclic dimeric GMP-bindingprotein that regulates surface attachment by Pseudomonas fluorescens Pf0-1. Proc. Natl. Acad. Sci. USA 2009, 106, 3461–3466. [Google Scholar]
- Whitney, J.C.; Colvin, K.M.; Marmont, L.S.; Robinson, H.; Parsek, M.R.; Howell, P.L. Structure of the Cytoplasmic Region of PelD, a Degenerate Diguanylate Cyclase Receptor That Regulates Exopolysaccharide Production in Pseudomonas aeruginosa. J. Biol. Chem. 2012, 287, 23582–23593. [Google Scholar] [CrossRef] [Green Version]
- Levi, A.; Folcher, M.; Jenal, U.; Shuman, H.A. Cyclic diguanylate signaling proteins control intracellular growth of Legionella pneumophila. mBio 2011, 2, e00310–e00316. [Google Scholar] [CrossRef] [Green Version]

| SN# | Genotype | Reference | |
|---|---|---|---|
| CR39 | L. pneumophila serogroup 1, strain LP01 rpsL | [30] | |
| CR58 | LP01 rpsL ΔdotA | [31] | |
| JR32 | L. pneumophila serogroup 1, rpsL | [32] | |
| SN300 | LP01 rpsL ΔbffA | This study | |
| SN306 | LP01 rpsL ΔbffA +pCM1 | This study | |
| SN307 | LP01 rpsL ΔbffA+ pCM2 | This study | |
| SN308 | LP01 rpsL ΔbffA + pCM3 | This study | |
| SN278 | JR32 ΔbffA | This study | |
| SN283 | JR32 ΔbffA + pCM2 | This study | |
| SN284 | JR32 ΔbffA + pCM3 | This study | |
| SN286 | JR32 ΔbffA + pCM1 | This study | |
| Plasmid | Important properties | Marker | Reference |
| pMMB207-M45NT | Amino-terminal M45 epitope tag vector | Cm | [33] |
| pSR47s | Gene replacement vector | Kan | [34] |
| pCM1 | pMMB207 empty vector-lacking PstI site in MCS | Cm | This study |
| pCM2 | pCM1 with full length bffA | Cm | This study |
| pCM3 | pMMB207-M45T with bffA(1-366) | Cm | This study |
| pCM4 | pSR47s-bffA | Kan | This study |
| Primers | Sequence | Sites | |
| SN252 | GCGTCTAGAATTTATTGTCCTTATTTTTATAGTC | XbaI | |
| SN253 | CGGGTAGGAGCAAATATTTACTTCAATCATAACG | ||
| SN254 | TAAATATTTGCTCCTACCCGAGGTGCTTAA | ||
| SN255 | CGCGAGCTCAACCTGCTTTGCTAAAACAAGA | SacI | |
| SN256 | GCGGGATCCttATGATTGAAGTAAATATTTGGTTA | BamHI | |
| SN257 | gcgaagcttTTAAGCACCTCGGGTAGGA | HindIII | |
Publisher’s Note: MDPI stays neutral with regard to jurisdictional claims in published maps and institutional affiliations. |
© 2022 by the authors. Licensee MDPI, Basel, Switzerland. This article is an open access article distributed under the terms and conditions of the Creative Commons Attribution (CC BY) license (https://creativecommons.org/licenses/by/4.0/).
Share and Cite
Marin, C.; Kumova, O.K.; Ninio, S. Characterization of a Novel Regulator of Biofilm Formation in the Pathogen Legionella pneumophila. Biomolecules 2022, 12, 225. https://doi.org/10.3390/biom12020225
Marin C, Kumova OK, Ninio S. Characterization of a Novel Regulator of Biofilm Formation in the Pathogen Legionella pneumophila. Biomolecules. 2022; 12(2):225. https://doi.org/10.3390/biom12020225
Chicago/Turabian StyleMarin, Courtney, Ogan K. Kumova, and Shira Ninio. 2022. "Characterization of a Novel Regulator of Biofilm Formation in the Pathogen Legionella pneumophila" Biomolecules 12, no. 2: 225. https://doi.org/10.3390/biom12020225
APA StyleMarin, C., Kumova, O. K., & Ninio, S. (2022). Characterization of a Novel Regulator of Biofilm Formation in the Pathogen Legionella pneumophila. Biomolecules, 12(2), 225. https://doi.org/10.3390/biom12020225

